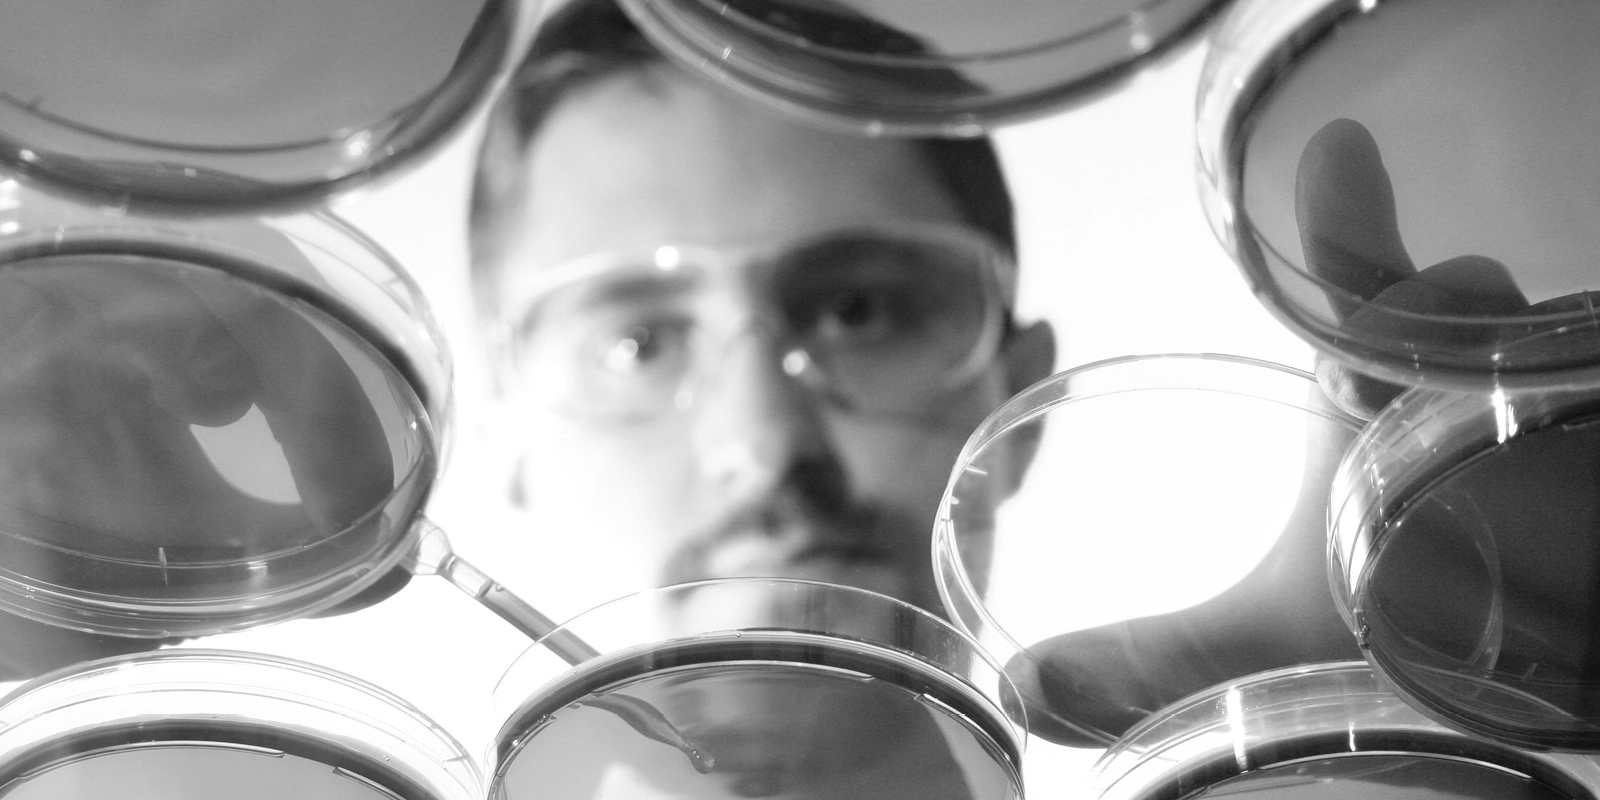

American Society for Clinical Pathology Board of Certification (ASCP BOC) credentials are a trusted mark of excellence, setting the standard for medical laboratory professionals and ensuring the highest quality of patient care.
For professionals, certification and qualification validate expertise, enhance career opportunities, and demonstrate a commitment to lifelong learning. They open doors to leadership roles, higher salaries, and global recognition. For patients, credentialed professionals ensure accurate testing, reliable results, and better health outcomes.